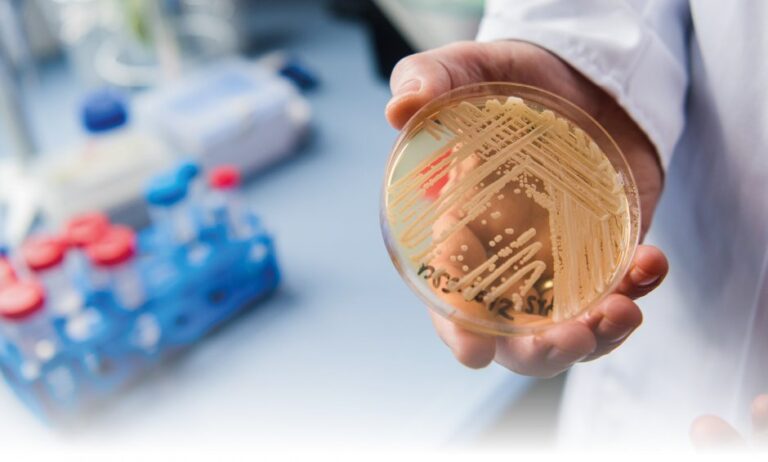
Μύκητας Candida auris: πόσο πρέπει να ανησυχούμε

Υγειονομικό πρωτόκολλο για τις Πανελλαδικές Εξετάσεις
Το πρωτόκολλο αναφορικά με τα υγειονομικά μέτρα που θα ισχύσουν κατά τη διενέργεια των Πανελλαδικών εξετάσεων 2022, καθώς επίσης και κατά την εξέταση των μουσικών

Το πρωτόκολλο αναφορικά με τα υγειονομικά μέτρα που θα ισχύσουν κατά τη διενέργεια των Πανελλαδικών εξετάσεων 2022, καθώς επίσης και κατά την εξέταση των μουσικών

Το άρθρο υπογράφει η Δρ. Ιωάννα Ταμπούρη, Δερματολόγος – Αφροδισιολόγος Ομίλου Affidea, Διδάκτωρ Ιατρικής του Πανεπιστημίου “Eberhard Karls University of Tuebingen” της Γερμανίας, πρ. Επιμελήτρια
Γράφει η Αριστέα Βελεγράκη Καθηγήτρια, Ιατρική Σχολή ΕΚΠΑ, Σύμβουλος και Υπεύθυνη Μυκητολογικού Εργαστηρίου του Ομίλου ΒΙΟΙΑΤΡΙΚΗ Ο μύκητας Candida auris (εν συντομία C. auris) πρωτοαπομονώθηκε

Το Τμήμα Διαδερμικών Βαλβίδων και η Β’ Καρδιοχειρουργική Κλινική του ΥΓΕΙΑ, υπό την αιγίδα του HEAL Academy και της Ελληνικής Καρδιολογικής Εταιρείας, συνδιοργανώνουν το 12ο

Τα άτομα με ρευματικές παθήσεις αποτελούν το μεγαλύτερο τμήμα του πληθυσμού που ζει με ιατρικές καταστάσεις μεγάλης χρονικής διάρκειας. Οι σοβαρές επιπτώσεις των παθήσεων αυτών